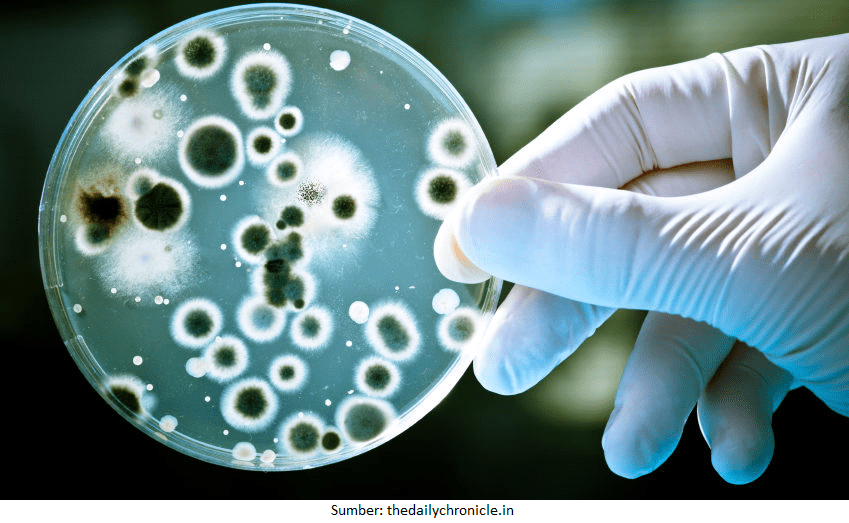

Materi Biologi - Bioteknologi Kelas 12 MIA - Belajar Pintar
BelajarPintarV3
Peta Belajar Bersama
Sebelum masuk ke materi bioteknologi, coba sobat pintar perhatikan apa yang perlu kita pelajari dari peta belajar bersama berikut ya....

Sudah di cek, Sobat? Sekarang waktunya kita mulai belajar bersama…
Bioteknologi

Bioteknologi berasal dua kata yaitu bios yang berarti hidup dan teknologi sehingga akan menghasilkan sebuah cabang ilmu baru yaitu Ilmu yang mempelajari mengenai bagaimana cara memanfaatkan makhluk hidup seperti jamur,bakteri, virus dan sebagainya yang dapat dimanfaatkan untuk kemaslahatan manusia di bumi ini.
Ilmu bioteknologi sudah sangat berkembang pesat yang pada awalnya hanya bioteknologi konvensional kini sudah merambah pada bioteknologi modern.
Tentu Sobat Pintar jadi penasaran tentang jenis teknologi yang satu ini kan? Yuk, kita pahami materi ini bersama.
Bioteknologi Modern


Sobat Pintar, bioteknologi modern merupakan bioteknologi yang menggunakan prinsip-prinsip ilmiah dengan teknik rekayasa genetika (DNA), mikrobiologi, dan biokimia.
Ciri-ciri bioteknologi modern, antara lain:
- steril
- produksi dalam jumlah lebih banyak
- kualitasnya standar dan terjamin
- memanfaatkan metode-metode modern bioteknologi

Kultur Jaringan
Kultur jaringan merupakan suatu teknik atau metode untuk mengisolasi bagian-bagian tanaman (sel, jaringan, atau organ seperti akar, batang, daun, dan pucuk) kemudian menumbuhkan bagian tersebut secara aseptis pada medium kultur secara in vitro. Dengan demikian, bagian-bagian tanaman tersebut dapat memperbanyak diri dan dapat menjadi tanaman lengkap kembali.
Isolasi atau pemisahan bagian tanaman dapat dilakukan secara mekanis maupun kimiawi (enzimatis). Kultur jaringan pada tanaman dapat dilakukan karena setiap tanaman mempunyai sifat totipotensi. Totipotensi adalah kemampuan sel tanaman untuk menjadi tanaman baru yang lengkap, jika ditumbuhkan dalam medium atau lingkungan yang sesuai.
Keuntungan kultur jaringan antara lain:
- untuk memperoleh bibit tanaman unggul dalam waktu singkat dan jumlah banyak
- tidak membutuhkan area yang luas
- sifat yang dikultur sesuai dengan induknya
Rekayasa Genetika
Tahun 1973 merupakan sejarah yang mengawali penelitian sebelum berkembangnya rekayasa genetika, yaitu pencangkokan gen mamalia ke dalam sel bakteri, sehingga menimbulkan fenotip maupun genotip yang baru. Teknik rekayasa genetika dapat dilakukan melalui Teknologi DNA Rekombinan, Transplantasi Nukleus, Kloning dan Teknologi Hibridoma.
footer_v3
Bersama Aku Pintar temukan jurusan kuliah yang tepat
sesuai minat dan bakatmu.
Aku Pintar memiliki visi membuat pendidikan merata, mudah dijangkau, dan terjangkau dengan Program Journey Pintar yang merupakan sebuah program persiapan lengkap bagi siswa SMA/SMK/sederajat yang ingin masuk ke perguruan tinggi impiannya.
Kontak Kami
Grand Slipi Tower Lt. 42
Jl. S. Parman Kav 22-24
Jakarta Barat
© 2024 Aku Pintar. All Rights Reserved